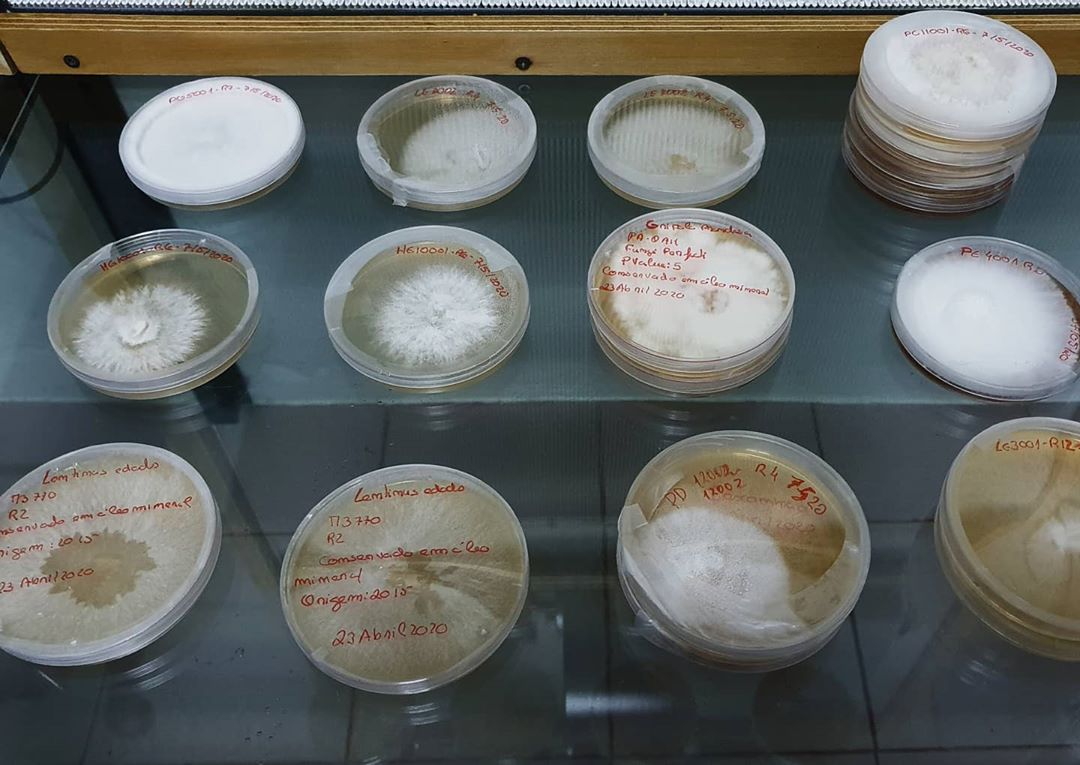

Laboratório/Micélio
Os laboratórios onde se produz micélio foram criados com vista à redução de contaminações nas culturas de fungos de modo a maximizar o sucesso na obtenção de cogumelos. Nos laboratórios mais avançados, as contaminações só surgem caso o operador não execute corretamente uma técnica ou se os equipamentos não estiverem a funcionar devidamente. É importante salientar que a maioria dos contaminantes é invisível a olho nu (esporos) e como tal, devem tomar-se medidas preventivas para evitar ao máximo a sua exposição. Caso estes apareçam devem ser de imediato eliminados.
Todas as culturas de cogumelos tiveram origem na natureza. Foram isoladas através de culturas de tecido ou de esporos e depois mantidas em bancos de culturas ou melhoradas através de um processo que habitualmente se designa melhoramento ou “breeding” de culturas. Uma vez isolada a cultura vai ser testada em produção para verificar se é produtiva e se os cogumelos têm as características pretendidas. As técnicas de produção variam com as exigências das espécies e com as matérias primas e equipamentos disponíveis. No caso de uma cultura ser considerada economicamente viável para produção então ela entra no banco de culturas comercializáveis.
A imagem a seguir evidencia todas as fases de isolamento de culturas e cultivo de cogumelos.
É extremamente difícil senão impossível criar uma cultura pura fora do laboratório pelo que é imprescindível que as primeiras fases decorram em ambiente o mais assético possível. Respeitando esta condição geram-se culturas puras em meio nutritivo com agar, em caixas de Petri.
O passo seguinte é a produção de micélio em grão, onde o meio nutritivo com agar, já colonizado pelo fungo, é transferido para grão de cereal esterilizado. Cada caixa de Petri pode inocular 1 a 2 frascos de grão e cada um destes pode inocular mais 5 a 20 frascos de grão.
O passo de inoculação do substrato não tem de ser feito necessariamente em ambiente estéril (laboratório). Dependendo do substrato a inocular, a palha de cereais, o serrim de madeira, o substrato compostado, os troncos de madeira, os canteiros de exterior ou a produção de cogumelos em povoamentos florestais poderá ser usado um ambiente mais ou menos assético.
| Kits com substrato de palha de cereais | Kits com substrato compostado (base de estrume e palha) |
Kits com substrato de serrim/troncos de madeira |
|---|---|---|
| Pleurotus ostreatus (cogumelo-ostra) | Agaricus bisporus (champignon-de-paris) | Lentinula edodes (shiitake) |
| (todo o ano) | (out-abr) | (todo o ano) |
| Pleurotus djamor (cogumelo-ostra-rosa) | Agaricus brunnescens (portobello) | Pleurotus eryngii (cogumelo-de-cardo) |
| (mai-out) | (out-abr) | (out-abr) |
| Pleurotus citrinopileatus (cogumelo-ostra-amarelo) | Lepista nuda (azulão) | Hericium erinaceus (juba-de-leão) |
| (mai-out) | (out-abr) | (out-abr) |
| Agrocybe aegerita Pholiota aegerita (cogumelo-do-choupo) |
Coprinus comatus (coprinu-cabeludo) | Grifola frondosa (maitake) |
| (todo o ano) | (out-abr) | (out-abr) |
| Stropharia rugosoannulata (rei) | - | Flammulina velutipes (enokitake) |
| (abr-out) | - | (abr-out) |
| Volvariella volvacea (cogumelo-da-palha) | - | Ganoderma lucidum (reishi) |
| (jun-set) | - | (abr-out) |
| Pleurotus pulmonarius (cogumelo-ostra-de-verão) | - | Auricularia auricula-judae (orelha-de-judas) |
| (abr-out) | - | (todo o ano) |
| - | - | Hypsizygus tessellatus (buna-shimeji) |
| - | - | (out-abr) |
| - | - | Trametes versicolor (cauda-de-peru) |
| - | - | (todo o ano) |

